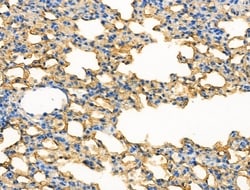
Invitrogen Phospho-LRP5 (Tyr1473) Polyclonal Antibody 100 &mu;L | Buy Online | Invitrogen&trade; | Fisher Scientific

missing translation for 'onlineSavingsMsg'
Learn More
Learn More
Invitrogen™ Phospho-LRP5 (Tyr1473) Polyclonal Antibody


Description
Antibody detects endogenous levels of LRP5 only when phosphorylated at Tyr1473.
LDL related proteins, LRP 5 and LRP 6, are members of the LDL receptor superfamily, which were found to be involved in the canonical Wnt signaling pathway. Mammalian LRP 6 was shown to bind to Wnt 1 and enhance Wnt-induced developmental processes in Xenopus embryos. Mice lacking LRP 6 exhibited developmental defects that are similar to those caused by deficiencies in various Wnt proteins. Recent work also shows that Wnt proteins induce the binding of LRP 5 to Axin, leading Axin degradation and beta catenin stabilization.

Specifications
Specifications
| Antigen | Phospho-LRP5 (Tyr1473) |
| Applications | Immunohistochemistry (Paraffin), Western Blot |
| Classification | Polyclonal |
| Concentration | 1 mg/mL |
| Conjugate | Unconjugated |
| Formulation | PBS with 50% glycerol and 0.02% sodium azide; pH 7.4 |
| Gene | LRP5 |
| Gene Accession No. | O75197, Q91VN0 |
| Gene Alias | BMND1; EVR1; EVR4; HBM; HGNC:6697; LDL receptor related protein 5; low density lipoprotein receptor-related protein 5; low density lipoprotein receptor-related protein 7; low-density lipoprotein receptor-related protein 5; Low-density lipoprotein receptor-related protein 7; LR3; Lrp5; LRP-5; LRP7; LRP-7; mKIAA4142; OPPG; OPS; OPTA1; VBCH2 |
| Gene Symbols | LRP5 |
| Show More |
Product Title
By clicking Submit, you acknowledge that you may be contacted by Fisher Scientific in regards to the feedback you have provided in this form. We will not share your information for any other purposes. All contact information provided shall also be maintained in accordance with our Privacy Policy.
Spot an opportunity for improvement?